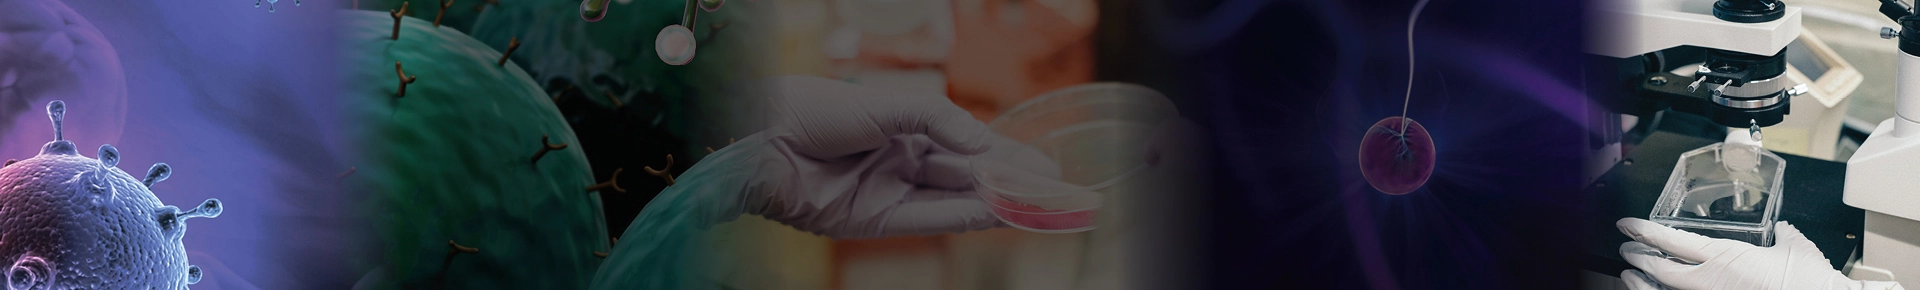

Компания BIOCAD внедрила подсистему материально-технического обеспечения производства
Отрасль : Фармацевтическая промышленность.
Исполнитель: Диалог Информационные Технологии
Функциональная область: Управление закупками (МТО). Управление логистикой и складом. Управление производством.
01.03.2016 - 01.07.2018
Центральный федеральный округ РФ
Северо-Западный федеральный округ РФ
Компания BIOCAD внедрила подсистему материально-технического обеспечения производства базе внедренного решения «1С:ERP управление предприятием». Уникальность проекта связана со сложной схемой консолидации информации территориально-распределенных производственных площадок и офисов компании по всему миру. В результате проекта внедрен механизм материально-технического обеспечения исследовательской деятельности по всему предприятию. В информационной системе ведется актуальная информация о складских остатках в лабораториях, что позволяет менеджерам по закупкам оперативно обеспечивать потребности под конкретный проект. Такой механизм позволил сократить временные трудозатраты сотрудников на 15%. Внедрен функционал поддержания неснижаемых остатков на складах организации. Это повысило точность планирования уровня запасов на 19%

Биотехнологическая компания BIOCAD — международная инновационная компания, объединившая научно-исследовательский центр, фармацевтическое и биотехнологическое производство, доклинические и международные клинические исследования. Она из немногих компаний полного цикла создания лекарственных препаратов: от поиска молекулы до массового производства и маркетинговой поддержки. В компании работают 2200 человек, из которых более 700 ученые и исследователи. Офисы расположены в США, Финляндии, Бразилии, Китае, Индии, и других странах.
Цель проекта: поддержать рост объемов производства и масштабов исследовательской деятельности.
Задачи проекта:
- Внедрение функционала поддержания неснижаемого запаса различных ТМЦ для беспрерывного производства и исследований.
- Организация функции консолидации потребностей из различных источников, таких как заказы на производство, заказы на внутреннее потребление, заказы клиентов и другие, в единой подсистеме обеспечения потребностей.
- Реализация комплексной автоматизации сквозных процессов, таких как производство. закупки, склад, продажи и подготовка фундамента для непрерывного развития системы.
Руководство приняло решение модернизировать информационную систему «1С:ERP Управление предприятием» по причине того, что рост объемов производства и масштабов исследовательской деятельности было сложно поддерживать с помощью существующей методологии (разовые заявки от каждого отдела без использования таких механизмов обеспечения как «Формирование заказов по потребностям» и «Состояние обеспечения»). Требовалась функциональность, позволяющая массово отрабатывать различные типы потребностей и отслеживать состояние каждого склада.
Подсистема обеспечения производства построена на базе «1С:ERP Управление предприятием».
Автоматизированы следующие функции:
- Закупки (снабжение) и управление отношениями с поставщиками:
- оформление заказов поставщикам;
- планирование закупок;
- управление отношениями с поставщиками;
- управление цепочками поставок;
- учет прихода ТМЦ.
- Производство, услуги:
- диспетчеризация производства на уровне цеха;
- объемно-календарное планирование производства;
- планирование потребности в материалах;
- расчет нормативной себестоимости;
- управление данными о составе и структура изделия, рецептура;
- управление ремонтами основных средств (CMM, EAM);
- учет затрат на производство.
- Расчет нормативной себестоимости заказов.
- Склад и логистика:
- контроль и учет серийных номеров, сроков годности и сертификатов;
- резервирование ТМЦ;
- управление складскими запасами;
- учет ТМЦ в цеховых кладовых.
Заказы клиентов формируются в web-интерфейсе системы B2B. Данные по заказам попадают в «1С:ERP Управление предприятием», где в дальнейшем обрабатываются менеджерами по продажам. Настроена двухсторонняя интеграция, учитывающая изменения статусов заказов.
Настроена бесшовная интеграция с «1С:Документооборот». Интеграция реализована для процессов согласования и исполнения:
- согласование потребностей по заказам на внутреннее потребление и заказам на ремонт,
- согласование заказов поставщику,
- согласование планов производства и изменений планов производства,
- согласование разрешений на замену,
- обновление потребностей производства с учетом согласованных замен.
Для работы с командами по сопровождению программных продуктов в компании используется система «1С:Система проектирования прикладных решений». Реализована интеграция этой системы с «1С:ERP Управление предприятием» в части данных пользователей. В «1С:Система проектирования прикладных решений» также попадают данные из системы учета заявок Заказчика (Help Desk), которые позволяют анализировать все закрытые задачи, попавшие в акты выполненных работ с точки зрения соблюдения уровня сервиса.

Схема архитектуры системы
Количество АРМ: 200. Среднее число подключений к базе: 170.
Быстрые организационные изменения и рост компании BIOCAD существенно повлияли на ход работы и особенности проекта — необходимо было оперативно вносить корректировки в систему, в зависимости от требований бизнеса. Ввиду этих особенностей, в процессе сопровождения проводились регулярные доработки и развитие существующей системы, а также была необходима постоянная профессиональная команда с широким перечнем компетенций по различным функциональным блокам для решения комплексных задач на стыке функциональных блоков.
Уникальность проекта связана со сложной схемой консолидации информации территориально-распределенных производственных площадок и офисов компании по всему миру:
- 6 офисов компании,
- 2 склада импортных подразделений,
- 26 исследовательских лабораторий,
- 4 производственных площадки.
В ходе проекта были выполнены работы по адаптации типового решения:
- Адаптация типовых рабочих мест по поддержанию складских запасов. Прослеживаемость индивидуальных заявок — статусы потребности и зоны ответственности.
- Развитие методики резервирования в состоянии обеспечения производства («Точно в срок»).
- Точность планирования запасов в хабах.
- Дополнительный контроль своевременности списаний ТМЦ в подразделениях.
- Внедрен механизм материально-технического обеспечения исследовательской деятельности по всему предприятию. В информационной системе ведется актуальная информация о складских остатках в лабораториях, что позволяет менеджерам по закупкам оперативно обеспечивать потребности под конкретный проект. Своевременное создание документов потребности в лабораториях позволяет также контролировать бюджет подразделений. Стоимость ТМЦ списывается на конкретный исследовательский проект, по информации возможна дальнейшая аналитика при планировании будущих бюджетов. Такой механизм позволил сократить временные трудозатраты сотрудников на 15%.
- Внедрен функционал поддержания неснижаемых остатков на складах организации. В результате увеличилась на 19% точность планирования уровня запасов на обеспечивающих складах за счет прозрачности консолидации потребностей подразделений и логистики обеспечения. Функционал позволяет учитывать длительность поставки в зависимости от различных вариантов обеспечивающей цепочки и гибко принимать решение о том, какой уровень запасов является необходимым и достаточным для бесперебойного функционирования подразделений.
- Внедрена функциональность оперативного обеспечения производства на производственных площадках Санкт-Петербурга. Поставленный в подразделениях производственный учет материалов позволяет корректно рассчитывать себестоимость продукции, планировать отгрузки с обеспечивающих складов, анализировать обеспеченность производства готовой продукции (на площадках в Москве), полуфабрикатами (субстанциями, производимыми в Санкт-Петербурге).
- Разработана функциональность для мониторинга метрик обеспечения потребностей. Существует возможность детального анализа бизнес-процесса обеспечения потребностей за счет пошаговой диагностики времени на выполнение каждой функции (разграничена аналитика по зонам ответственности кладовщика и менеджера по закупкам).
На сегодняшний день система находится на сопровождении и развитии. В качестве ключевых задач развития системы выделены следующие работы:
- Внедрение блока планирования и функционала анализа сбалансированности продаж, производства и обеспечения
- Развитие процессов долгосрочного обеспечения потребностей (производства и внутреннего потребления)
- Внедрение процессов учета ремонтов
- Оптимизация нормативных данных по обеспечению на основе собранной за время сопровождения системы статистики.